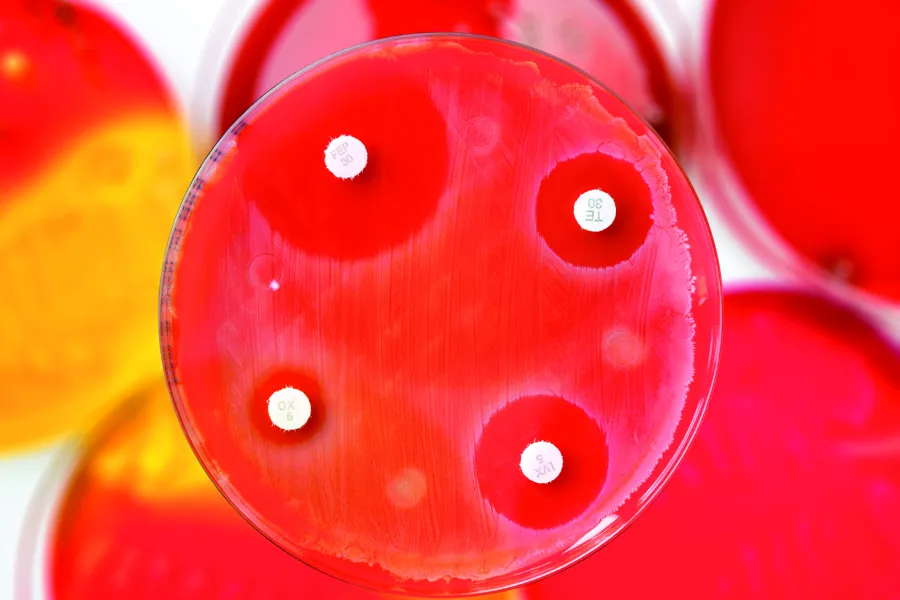
Røde dyrkningsskåler for bakterier med antibiotikatabletter

Resistensrapporter basert på MSIS-data
Publisert 02.01.2025
Sist oppdatert 03.01.2025
Foto: ECDC
Høsten 2024 lanserte FHI rapportsider for forekomst av antibiotikaresistente bakterier og sopp, samt Clostridioides difficile-infeksjoner. Agens med spesiell betydning for smittevern i helsetjenesten er valgt ut.
Rapportene er basert på FHIs Meldingssystem for smittsomme sykdommer (MSIS) med laboratoriedata og epidemiologiske data fra behandlende leger. Rapportene filtrerer således på forhold som helseregion, smittested og pasientenes alder. Sidene vil oppdateres jevnlig med en større, årlig oppdatering, vanligvis i april.
Her er rapportsidene: Forekomst av antibiotikaresistente bakterier og sopp - FHI